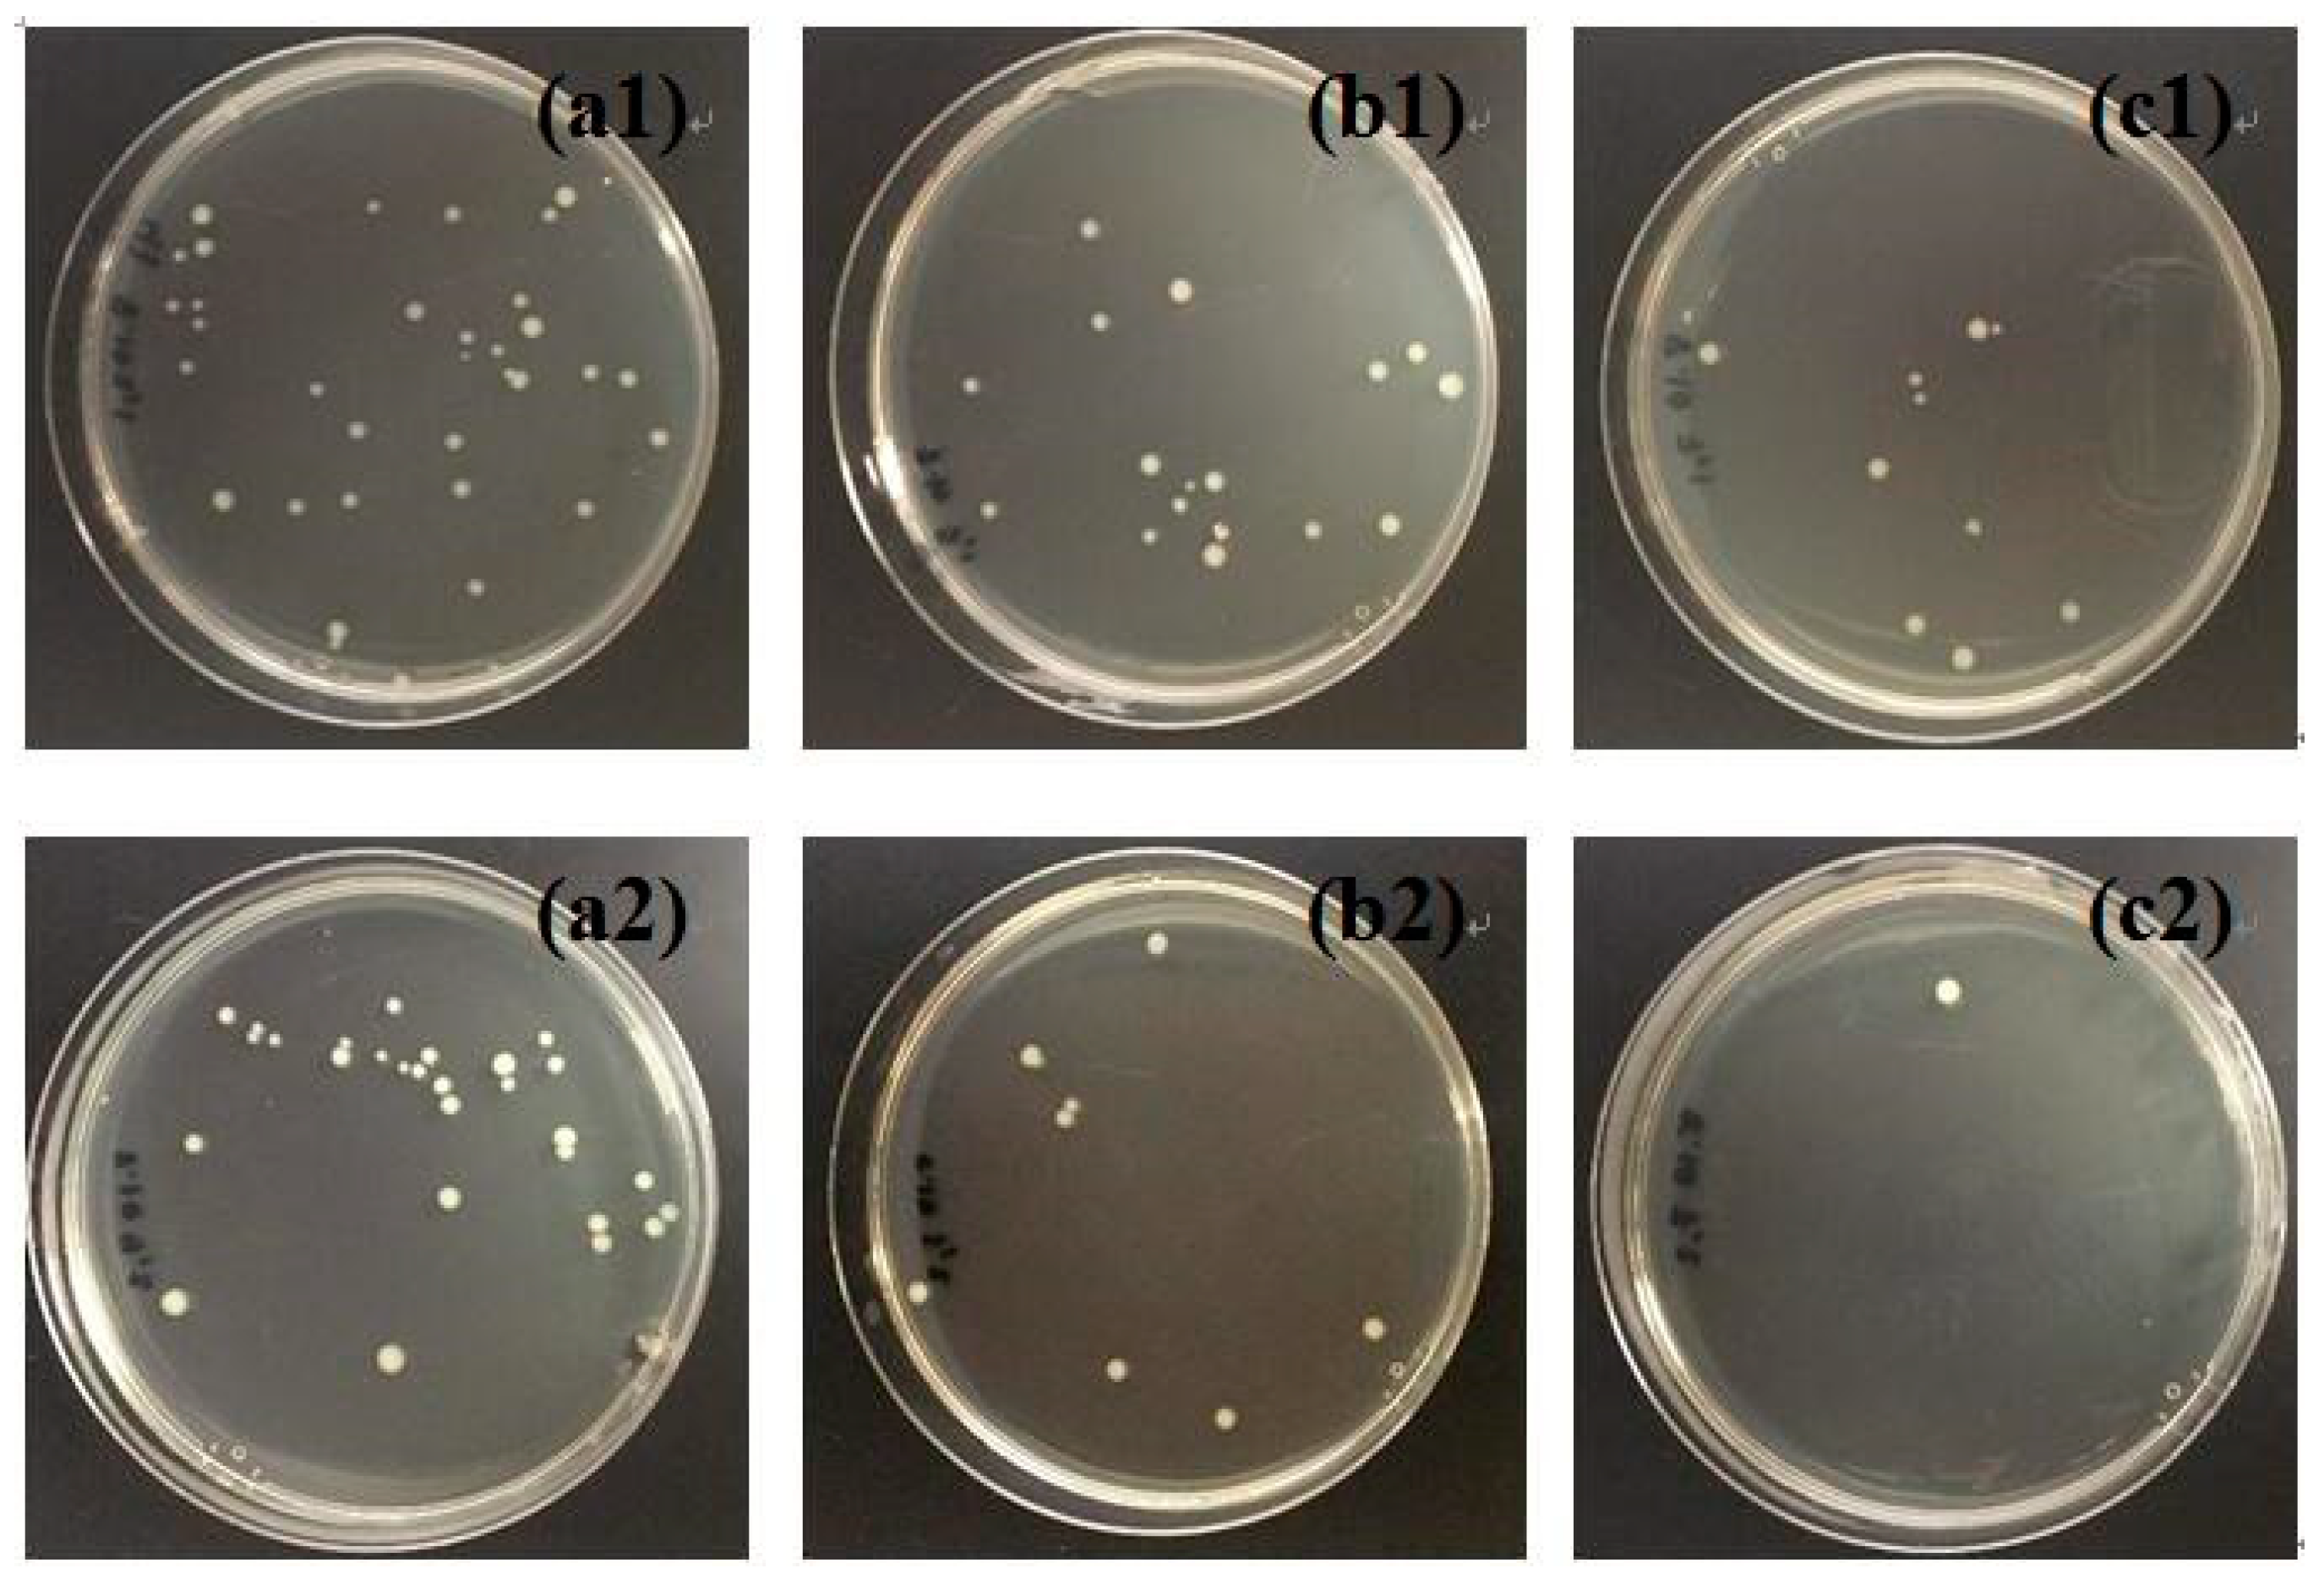
Polymers 10 01052 g009

Nanocomposite Film Containing Fibrous Cellulose Scaffold and Ag/TiO2 Nanoparticles and Its Antibacterial Activity
Abstract
:1. Introduction
2. Materials and Methods
2.1. Materials
2.2. Preparation of TiO2 Sol
2.3. Preparation of Ag/TiO2 Sol
2.4. Ag/TiO2/Cellulose Composite Film Fabrication
2.5. Scanning Electron Microscope (SEM)
2.6. Thermal Gravitational Analysis (TGA)
2.7. X-ray Diffraction (XRD)
2.8. Zeta-Potential
2.9. Transmission Electron Microscopy (TEM)
2.10. Preparation of PBS
2.11. Preparation of E. coli
2.12. Preparation of LB/Agar Plates
2.13. Antibacterial Test
3. Results and Discussion
3.1. Preparation of Ag/TiO2/Cellulose Composite Films
3.2. Structure and Morphology Characterization of Ag/TiO2/cellulose Composite Films
3.3 Antibacterial Activities
4. Conclusions
Author Contributions
Funding
Acknowledgments
Conflicts of Interest
References
- Klemm, D.; Heublein, B.; Fink, H.P.; Bohn, A. Cellulose: Fascinating biopolymer and sustainable raw material. Angew. Chem. Int. Ed. 2005, 44, 3358–3393. [Google Scholar] [CrossRef] [PubMed]
- Moon, R.J.; Martini, A.; Nairn, J.; Simonsen, J.; Youngblood, J. Cellulose nanomaterials review: Structure, properties and nanocomposites. Chem. Soc. Rev. 2011, 40, 3941–3994. [Google Scholar] [CrossRef] [PubMed]
- Ma, H.Y.; Burger, C.; Hsiao, B.S.; Chu, B. Ultrafine Polysaccharide Nanofibrous Membranes for Water Purification. Biomacromolecules 2011, 12, 970–976. [Google Scholar] [CrossRef] [PubMed]
- Mohammed, N.; Grishkewich, N.; Tam, K.C. Cellulose nanomaterials: Promising sustainable nanomaterials for application in water/wastewater treatment processes. Environ. Sci. Nano 2018, 5, 623–658. [Google Scholar] [CrossRef]
- Carpenter, A.W.; de Lannoy, C.F.; Wiesner, M.R. Cellulose Nanomaterials in Water Treatment Technologies. Environ. Sci. Technol. 2015, 49, 5277–5287. [Google Scholar] [CrossRef] [PubMed] [Green Version]
- Cheng, Q.Y.; Ye, D.D.; Yang, W.T.; Zhang, S.H.; Chen, H.Z.; Chang, C.Y.; Zhang, L.N. Construction of Transparent Cellulose-Based Nanocomposite Papers and Potential Application in Flexible Solar Cells. ACS Sustain. Chem. Eng. 2018, 6, 8040–8047. [Google Scholar] [CrossRef]
- Shchipunov, Y.; Postnova, I. Cellulose Mineralization as a Route for Novel Functional Materials. Adv. Funct. Mater. 2018, 28, 28. [Google Scholar] [CrossRef]
- Jia, C.; Li, T.; Chen, C.J.; Dai, J.Q.; Kierzewski, I.M.; Song, J.W.; Li, Y.J.; Yang, C.P.; Wang, C.W.; Hu, L.B. Scalable, anisotropic transparent paper directly from wood for light management in solar cells. Nano Energy 2017, 36, 366–373. [Google Scholar] [CrossRef]
- Wang, X.D.; Yao, C.H.; Wang, F.; Li, Z.D. Cellulose-Based Nanomaterials for Energy Applications. Small 2017, 13, 1–19. [Google Scholar] [CrossRef] [PubMed]
- Peng, Z.Y.; Zou, Y.B.; Xu, S.Q.; Zhong, W.B.; Yang, W.T. High-Performance Biomass-Based Flexible Solid-State Supercapacitor Constructed of Pressure-Sensitive Lignin-Based and Cellulose Hydrogels. ACS Appl. Mater. Interf. 2018, 10, 22190–22200. [Google Scholar] [CrossRef] [PubMed]
- Bu, Y.; Cao, M.L.; Jiang, Y.Y.; Gao, L.; Shi, Z.J.; Xiao, X.; Wang, M.K.; Yang, G.; Zhou, Y.H.; Shen, Y. Ultra-thin bacterial cellulose/poly(ethylenedioxythiophene) nanofibers paper electrodes for all-solid-state flexible supercapacitors. Electrochim. Acta 2018, 271, 624–631. [Google Scholar] [CrossRef]
- Neely, A.N.; Maley, M.P. Survival of enterococci and staphylococci on hospital fabrics and plastic. J. Clin. Microbiol. 2000, 38, 724–726. [Google Scholar] [PubMed]
- Iyigundogdu, Z.U.; Demir, O.; Asutay, A.B.; Sahin, F. Developing Novel Antimicrobial and Antiviral Textile Products. Appl. Biochem. Biotechnol. 2017, 181, 1155–1166. [Google Scholar] [CrossRef] [PubMed]
- Rai, M.; Yadav, A.; Gade, A. Silver nanoparticles as a new generation of antimicrobials. Biotechnol. Adv. 2009, 27, 76–83. [Google Scholar] [CrossRef] [PubMed]
- Morones, J.R.; Elechiguerra, J.L.; Camacho, A.; Holt, K.; Kouri, J.B.; Ramirez, J.T.; Yacaman, M.J. The bactericidal effect of silver nanoparticles. Nanotechnology 2005, 16, 2346–2353. [Google Scholar] [CrossRef] [PubMed]
- Richard, L.D.; Samuel, F.E. The development and functions of silver in water purification and disease control. Catal. Today 1997, 36, 107–114. [Google Scholar]
- Dankovich, T.A.; Gray, D.G. Bactericidal paper impregnated with silver nanoparticles for point-of-use water treatment. Environ. Sci. Technol. 2011, 45, 1992–1998. [Google Scholar] [CrossRef] [PubMed]
- Park, S.-H.; Ko, Y.-S.; Park, S.-J.; Lee, J.S.; Cho, J.; Baek, K.-Y.; Kim, I.T.; Woo, K.; Lee, J.-H. Immobilization of silver nanoparticle-decorated silica particles on polyamide thin film composite membranes for antibacterial properties. J. Membr. Sci. 2016, 499, 80–91. [Google Scholar] [CrossRef]
- Regiel, A.; Irusta, S.; Kyziol, A.; Arruebo, M.; Santamaris, J. Preparation and characterization of chitosan-silver nanocomposite films and their antibacterial activity against staphylococcus aureus. Nanotechnology 2013, 24, 1–13. [Google Scholar] [CrossRef] [PubMed]
- Daoud, W.A.; Xin, J.H.; Zhang, Y.-H. Surface functionalization of cellulose fibers with titanium dioxide nanoparticles and their combined bactericidal activities. Surf. Sci. 2005, 599, 69–75. [Google Scholar] [CrossRef]
- Chauhan, I.; Mohanty, P. In situ decoration of TiO2 nanoparticles on the surface of cellulose fibers and study of their photocatalytic and antibacterial activities. Cellulose 2014, 22, 507–519. [Google Scholar] [CrossRef]
- Abdel Rehim, M.H.; El-Samahy, M.A.; Badawy, A.A.; Mohram, M.E. Photocatalytic activity and antimicrobial properties of paper sheets modified with TiO2/Sodium alginate nanocomposites. Carbohydr. Polym. 2016, 148, 194–199. [Google Scholar] [CrossRef] [PubMed]
- Luo, Y.; Huang, J.G. Hierarchical-Structured Anatase-Titania/Cellulose Composite Sheet with High Photocatalytic Performance and Antibacterial Activity. Chemistry 2015, 21, 2568–2575. [Google Scholar] [CrossRef] [PubMed]
- Perkas, N.; Lipovsky, A.; Amirian, G.; Nitzan, Y.; Gedanken, A. Biocidal properties of TiO2 powder modified with Ag nanoparticles. J. Mater. Chem. B 2013, 1, 5309–5316. [Google Scholar] [CrossRef]
- Pan, X.; Medina-Ramirez, I.; Mernaugh, R.; Liu, J. Nanocharacterization and bactericidal performance of silver modified titania photocatalyst. Colloid Surf. B 2010, 77, 82–89. [Google Scholar] [CrossRef] [PubMed]
- Abdel-Fatah, W.I.; Gobara, M.M.; Mustafa, S.F.M.; Ali, G.W.; Guirguis, O.W. Role of silver nanoparticles in imparting antimicrobial activity of titanium dioxide. Mater. Lett. 2016, 179, 190–193. [Google Scholar] [CrossRef]
- Thiel, J.; Pakstis, L.; Buzby, S.; Raffi, M.; Ni, C.; Pochan, D.J.; Shah, S.I. Antibacterial properties of silver-doped titania. Small 2007, 3, 799–803. [Google Scholar] [CrossRef] [PubMed]
- Cacciato, G.; Bayle, M.; Pugliara, A.; Bonafos, C.; Zimbone, M.; Privitera, V.; Grimaldi, M.G.; Carles, R. Enhancing carrier generation in TiO2 by a synergistic effect between plasmon resonance in Ag nanoparticles and optical interference. Nanoscale 2015, 7, 13468–13476. [Google Scholar] [CrossRef] [PubMed]
- Ali, T.; Ahmed, A.; Alam, U.; Uddin, I.; Tripathi, P.; Muneer, M. Enhanced photocatalytic and antibacterial activities of Ag-doped TiO2 nanoparticles under visible light. Mater. Chem. Phys. 2018, 212, 325–335. [Google Scholar] [CrossRef]
- Hussain, M.; Tariq, S.; Ahmad, M.; Sun, H.Y.; Maaz, K.; Ali, G.; Hussain, S.Z.; Iqbal, M.; Karim, S.; Nisar, A. Ag-TiO2 nanocomposite for environmental and sensing applications. Mater. Chem. Phys. 2016, 181, 194–203. [Google Scholar] [CrossRef]
- Liu, H.; Dong, X.N.; Nan, L.; Ma, H.X.; Chen, X.J.; Zhu, Z.F. A novel fabrication of silver-modified TiO2 colloidal-assembled microstructures and enhanced visible photocatalytic activities. Mater. Lett. 2015, 159, 142–145. [Google Scholar] [CrossRef]
- Xu, H.F.; Li, G.; Liu, N.; Zhu, K.R.; Zhu, G.; Jin, S.W. Ag @ hierarchical TiO2 core-shell nanostructures for enhanced photocatalysis. Mater. Lett. 2015, 142, 324–327. [Google Scholar] [CrossRef]
- Zhang, F.L.; Cheng, Z.Q.; Cui, L.Y.; Duan, T.T.; Anan, A.; Zhang, C.F.; Kang, L.J. Controllable synthesis of Ag@TiO2 heterostructures with enhanced photocatalytic activities under UV and visible excitation. RSC Adv. 2016, 6, 1844–1850. [Google Scholar] [CrossRef]
- Wang, D.; Zhou, Z.-H.; Yang, H.; Shen, K.-B.; Huang, Y.; Shen, S. Preparation of TiO2 loaded with crystalline nano Ag by a one-step low-temperature hydrothermal method. J. Mater. Chem. 2012, 22, 16306–16311. [Google Scholar] [CrossRef]
- Yu, D.H.; Yu, X.; Wang, C.; Liu, X.C.; Xing, Y. Synthesis of natural cellulose-templated TiO2/Ag nanosponge composites and photocatalytic properties. ACS Appl. Mater. Interfaces 2012, 4, 2781–2787. [Google Scholar] [CrossRef] [PubMed]
- Ginter, J.; Kisielewska, A.; Spilarewicz-Stanek, K.; Cichomski, M.; Batory, D.; Piwonski, I. Tuning of the photocatalytic activity of thin titanium dioxide coatings by highly ordered structure and silver nanoparticles. Microporous Mesoporous Mater. 2016, 225, 580–589. [Google Scholar] [CrossRef]
- Mahy, J.G.; Lambert, S.D.; Leonard, G.L.M.; Zubiaur, A.; Olu, P.Y.; Mahmoud, A.; Boschini, F.; Heinrichs, B. Towards a large scale aqueous sol–gel synthesis of doped TiO2: Study of various metallic dopings for the photocatalytic degradation of p-nitrophenol. J. Photochem. Photobiol. A 2016, 329, 189–202. [Google Scholar] [CrossRef]
- Li, S.; Huang, J.G. Cellulose-Rich Nanofiber-Based Functional Nanoarchitectures. Adv. Mater. 2016, 28, 1143–1158. [Google Scholar] [CrossRef] [PubMed]
- Cai, H.; Mu, W.; Liu, W.; Zhang, X.; Deng, Y. Sol–gel synthesis highly porous titanium dioxide microspheres with cellulose nanofibrils-based aerogel templates. Inorg. Chem. Commun. 2015, 51, 71–74. [Google Scholar] [CrossRef]
- Galkina, O.L.; Sycheva, A.; Blagodatskiy, A.; Kaptay, G.; Katanaev, V.L.; Seisenbaeva, G.A.; Kessler, V.G.; Agafonov, A.V. The sol–gel synthesis of cotton/TiO2 composites and their antibacterial properties. Surf. Coat. Technol. 2014, 253, 171–179. [Google Scholar] [CrossRef]
- Daoud, W.A.; Xin, J.H. Nucleation and Growth of Anatase Crystallites on Cotton Fabrics at low temperature. J. Am. Ceram. Soc. 2004, 87, 953–955. [Google Scholar] [CrossRef]
- Ludivine, M.; Rémi, D.; Ryan, J.M.; Lawrence, A.H.; Bertrand, D.; Christopher, B.M. One-step green synthesis of gold and silver nanoparticles with ascorbic acid and their versatile surface post-functionalization. RSC Adv. 2016, 6, 33092–33100. [Google Scholar]
- Pantaroto, H.N.; Ricomini, A.P.; Bertolini, M.M.; da Silva, J.H.D.; Neto, N.F.A.; Sukotjo, C.; Rangel, E.C.; Barao, V.A.R. Antibacterial photocatalytic activity of different crystalline TiO2 phases in oral multispecies biofilm. Dent. Mater. 2018, 34, E182–E195. [Google Scholar] [CrossRef] [PubMed]
- Li, W.; Bai, Y.; Liu, C.; Yang, Z.; Feng, X.; Lu, X.; van der Laak, N.K.; Chan, K.-Y. Highly Thermal Stable and Highly Crystalline Anatase TiO2 for Photocatalysis. Environ. Sci. Technol. 2009, 43, 5423–5428. [Google Scholar] [CrossRef] [PubMed]
- Tanaka, K.; Capule, M.F.V.; Hisanaga, T. Effect of crystallinity of TiO2 on its photocatalytic action. Chem. Phys. Lett. 1991, 187, 73–76. [Google Scholar] [CrossRef]
- Shuai, C.; Shuai, C.; Feng, P.; Gao, C.; Peng, S.; Yang, Y. Antibacterial Capability, Physicochemical Properties, and Biocompatibility of nTiO2 Incorporated Polymeric Scaffolds. Polymers 2018, 10, 328. [Google Scholar] [CrossRef]

© 2018 by the authors. Licensee MDPI, Basel, Switzerland. This article is an open access article distributed under the terms and conditions of the Creative Commons Attribution (CC BY) license (http://creativecommons.org/licenses/by/4.0/).
Share and Cite
Li, Y.; Tian, J.; Yang, C.; Hsiao, B.S. Nanocomposite Film Containing Fibrous Cellulose Scaffold and Ag/TiO2 Nanoparticles and Its Antibacterial Activity. Polymers 2018, 10, 1052. https://doi.org/10.3390/polym10101052
Li Y, Tian J, Yang C, Hsiao BS. Nanocomposite Film Containing Fibrous Cellulose Scaffold and Ag/TiO2 Nanoparticles and Its Antibacterial Activity. Polymers. 2018; 10(10):1052. https://doi.org/10.3390/polym10101052
Chicago/Turabian StyleLi, Yanxiang, Jessica Tian, Chuanfang Yang, and Benjamin S. Hsiao. 2018. "Nanocomposite Film Containing Fibrous Cellulose Scaffold and Ag/TiO2 Nanoparticles and Its Antibacterial Activity" Polymers 10, no. 10: 1052. https://doi.org/10.3390/polym10101052




